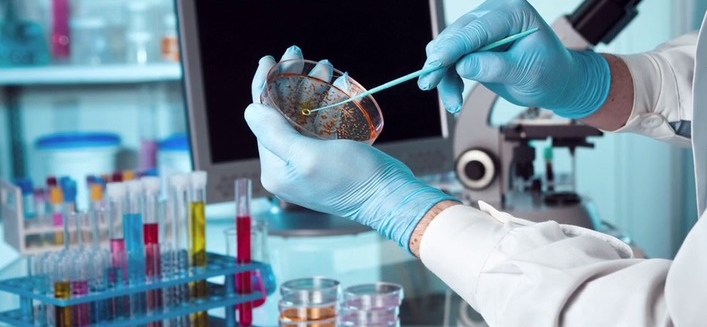

MEDICAL MERIMNA CENTER ΔΙΑΓΝΩΣΤΙΚΑ ΚΕΝΤΡΑ
Πυθίας 1 / Αθήνα / ΑΤΤΙΚΗΣ
ΜΙΚΡΟΒΙΟΛΟΓΙΚΟ ΕΡΓΑΣΤΗΡΙΟ ΑΘΗΝΑ ΒΙΟΠΑΘΟΛΟΓΟΣ ΜΙΚΡΟΒΙΟΛΟΓΟΣ, ΑΘΗΝΑ ΑΤΤΙΚΗ
Κατηγορία |
ΥΓΕΙΑ - ΙΑΤΡΟΙ |
Υποκατηγορία |
Διαγνωστικά Κέντρα |
Τηλέφωνο |
2108649085 |
Τηλ.2 - Φάξ |
6945930941 |
Άλλα τηλέφωνα |
6984474887 |
Email |
info@medicalmerimnacenter.gr
|
Άλλα Email |
kat.leontariti@gmail.com |
Ιστοσελίδα |
http://WWW.medicalmerimnacenter.gr |
Κοινωνικά δίκτυα |
|
MEDICAL MERIMNA CENTER ΔΙΑΓΝΩΣΤΙΚΑ ΚΕΝΤΡΑ

Κατηγορία
Τηλέφωνο
Φάξ
Email
Ιστοσελίδα
Κοινωνικά δίκτυα